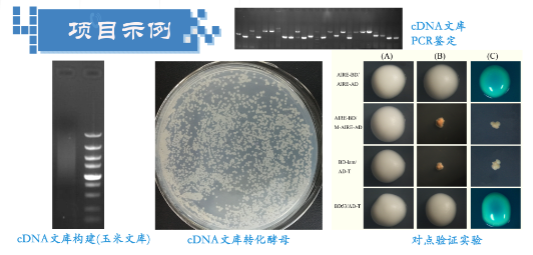

酵母双杂
技术简介
蛋白的酵母双杂交实验是以酵母的遗传分析为基础,研究蛋白间相互作用的一种有效技术手段。转录活化蛋白可以和DNA 上特异的序列结合而启动相应基因的转录反应。这种DNA 结合与转录激活的功能是由其上两个相互独立的结构域,即DNA 结合结构域(Binding Domain, BD)和转录活化结构域(Activation Domain, AD)共同完成的。
以Gal4 系统为例,BD和AD 分别由Gal4 蛋白上不同的两个结构域(1-147aa 与768-881aa)构成。在利用GAL4 系统筛选cDNA 文库或研究蛋白间的相互作用时,DNA 结合结构域与靶蛋白即"诱饵"相结合,转录活化结构域与文库蛋白或要验证的蛋白相结合。一般情况下,单独的BD 可以与GAL4 上游活化序列(GAL UAS)结合但不能引起转录,单独的AD 则不能与GAL UAS 结合;只有当BD 与 AD 分别表达的融合蛋白由于相互作用而导致两者在空间上相互靠近时,BD 与AD 才能与 GAL UAS结合并且引起报道基因的转录,从而激活下游报告基因,通过这一系列实验来验证两个蛋白之间的相互作用。
服务内容
| 项目分类 | 服务内容 |
| 酵母双杂交文库构建 | 双链cDNA转化AH109酵母感受态细胞,收集转化子及检测文库质量 |
| 诱饵载体的构建 | 将目的基因构建至PGBKT7 |
| 酵母双杂交筛选及鉴定 | 文库质粒和诱饵质粒共转酵母感受态细胞,筛选分析互作结果 |
| 点对点验证 | 构建诱饵BD质粒、目的蛋白AD质粒共转化AH109酵母, 检验两蛋白是否相互作用 |
技术优势
1. 专业的技术团队使您的实验高效、准确;
2. 丰富的分子实验基础,尤其在酵母杂交中积累了大量的实践经验,有成熟的实验技术,满足客户不同的实验需求
服务流程(图)
酵母双杂交文库构建——诱饵载体构建——诱饵载体自激活检测——文库质粒和诱饵质粒共转酵母感受态细胞——文库筛选、分析

您需要提供以下材料
1. 新鲜组织材料、冻存材料或高质量RNA、诱饵基因的模板
2. 尽可能全面的实验相关信息
交付数据及产品
1. 构建好的双杂交文库甘油菌:
1)文库容量≥106;
2)文库滴度>107cfu/ml;
3)插入片段平均大于500bp(不同物种略有差别);
4)减低高丰度表达基因10-100倍;
2. 酵母双杂交筛选得到的阳性克隆;
3. 实验过程报告及相关数据图片
实验结果图片示例: